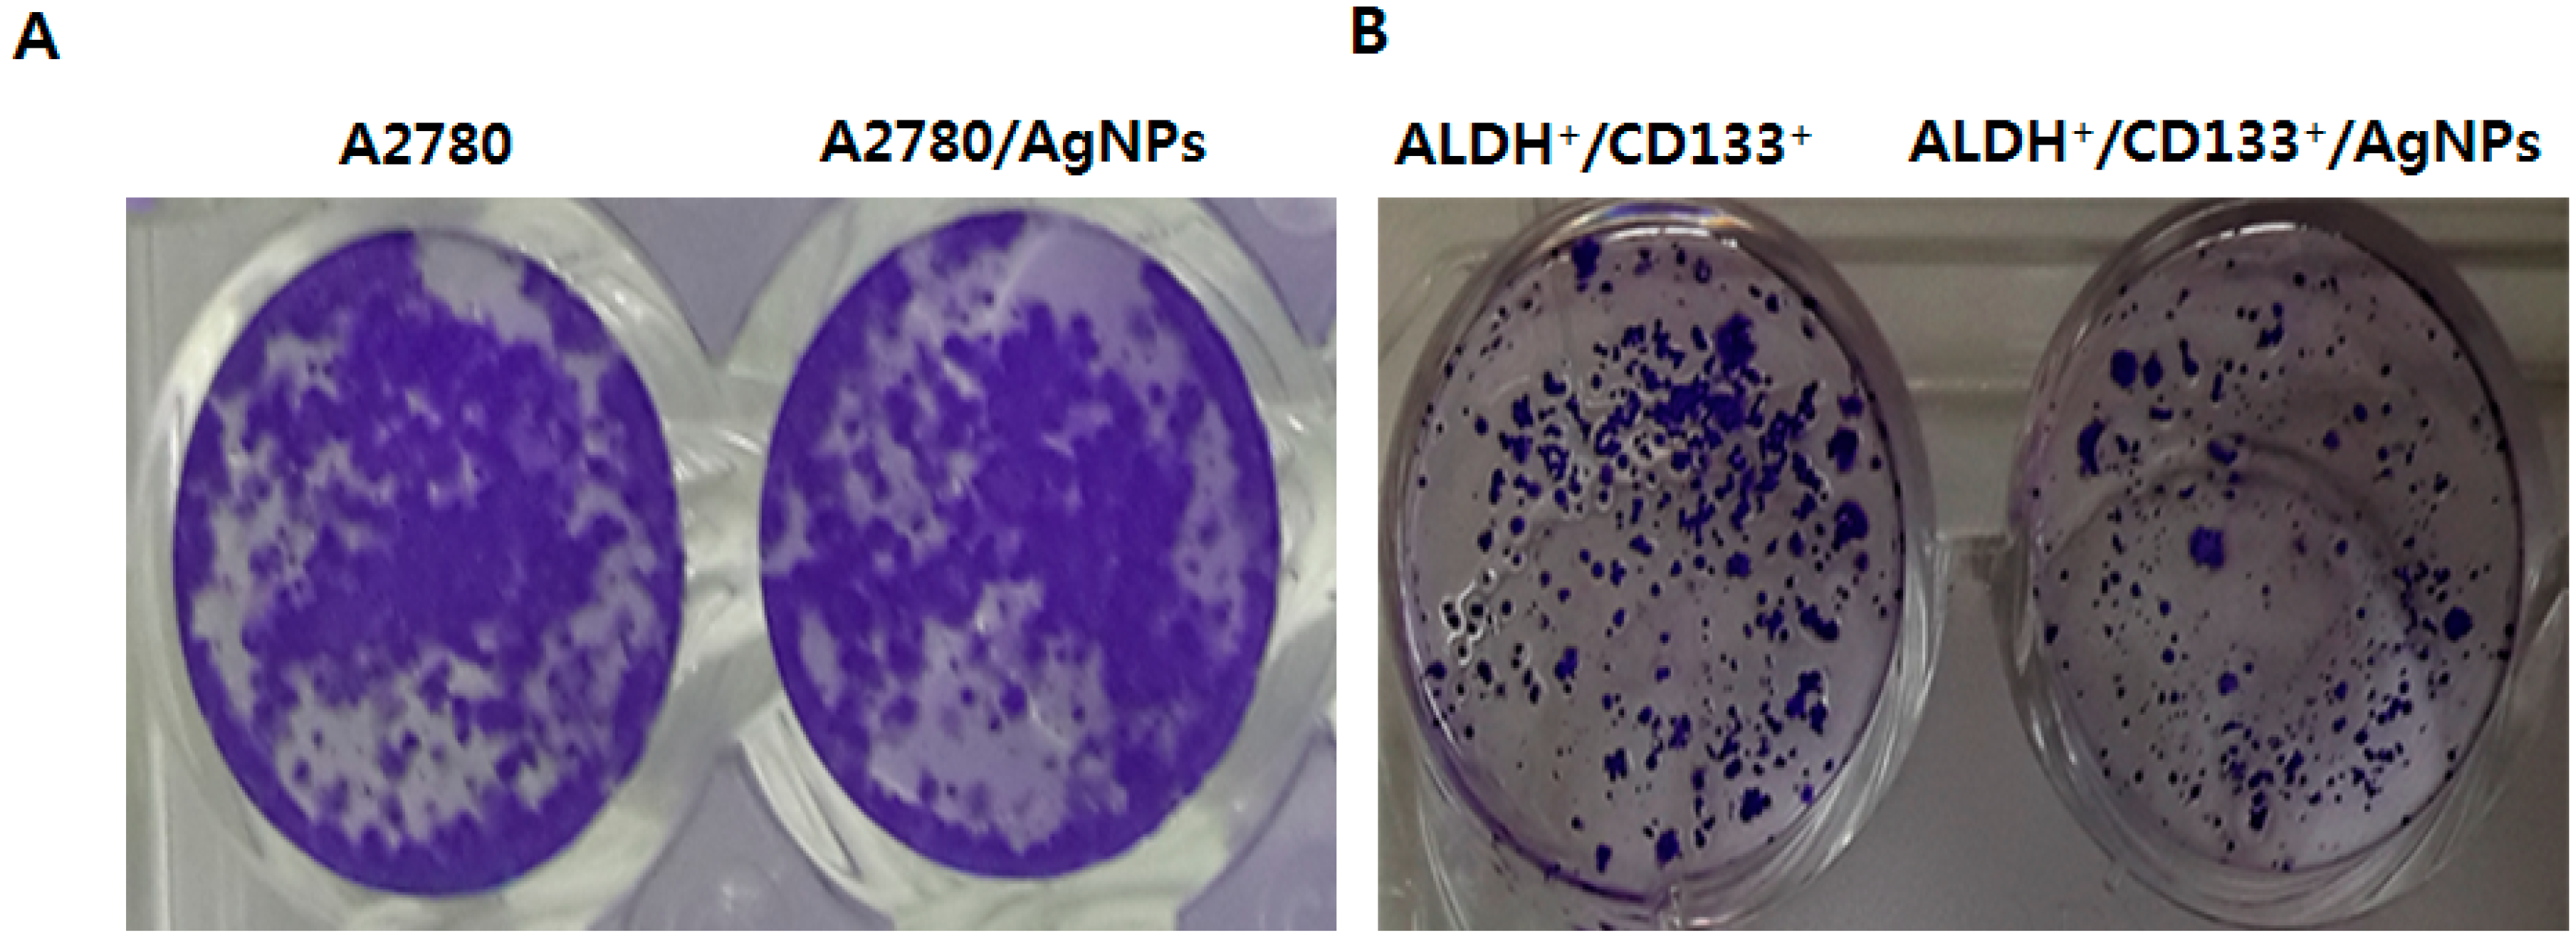

Differential Cytotoxic Potential of Silver Nanoparticles in Human Ovarian Cancer Cells and Ovarian Cancer Stem Cells
Abstract
:1. Introduction
2. Results and Discussion
2.1. Characterization of Silver Nanoparticles (AgNPs)
2.2. AgNPs Induce Dose- and Time-Dependent Effects on Cell Viability in Human Ovarian Cancer Cells
2.3. Isolation and Characterization of Cancer Stem Cells (CSCs)
2.4. Effect of AgNPs on OvCSCs
2.5. Cytotoxic Effects of AgNPs on A2780 and OvCSCs
2.6. AgNPs Inhibit Colonies Formation
2.7. AgNPs Induce Differential Apoptotic Responses in Bulk Cells (A2780) and OvCSCs (ALDH+/CD133+)
3. Materials and Methods
3.1. AgNPs Characterization
3.2. Cell Culture and Exposure to AgNPs
3.3. Flow Cytometry Analysis and Fluorescence-Activated Cell Sorting (FACS)
3.4. Cell Viability (CCK-8 Assay)
3.5. Reactive Oxygen Species Assay (DCFH-DA)
3.6. Mitochondrial Transmembrane Potential Assay (JC-1)
3.7. Clonogenic Assay
3.8. RT-PCR Analysis
4. Conclusions
Acknowledgments
Author Contributions
Conflicts of Interest
References
- What Are The Key Statistics about Ovarian Cancer? Available online: http://www.cancer.org/cancer/ovariancancer/detailedguide/ovarian-cancer-key-statistics (accessed on 5 January 2016).
- Vargas, A.N. Natural history of ovarian cancer. Ecancermedicalscience 2014, 8, 465. [Google Scholar] [PubMed]
- Bratasz, A.; Weir, N.M.; Parinandi, N.L.; Zweier, J.L.; Sridhar, R.; Ignarro, L.J.; Kuppusamy, P. Reversal to cisplatin sensitivity in recurrent human ovarian cancer cells by NCX-4016, a nitro derivative of aspirin. Proc. Natl. Acad. Sci. USA 2006, 103, 3914–3919. [Google Scholar] [CrossRef] [PubMed]
- McGuire, W.P.; Hoskins, W.J.; Brady, M.F.; Kucera, P.R.; Partridge, E.E.; Look, K.Y.; Clarke-Pearson, D.L.; Davidson, M. Cyclophosphamide and cisplatin compared with paclitaxel and cisplatin in patients with stage III and stage IV ovarian cancer. N. Engl. J. Med. 1996, 334, 1–6. [Google Scholar] [CrossRef] [PubMed]
- Blagden, S.P. Harnessing pandemonium: The clinical implications of tumor heterogeneity in ovarian cancer. Front. Oncol. 2015, 5, 149. [Google Scholar] [CrossRef] [PubMed]
- Eisenhauer, E.A.; Vermorken, J.B.; van Glabbeke, M. Predictors of response to subsequent chemotherapy in platinum pretreated ovarian cancer: A multivariate analysis of 704 patients (seecomments). Ann. Oncol. 1997, 8, 963–968. [Google Scholar] [CrossRef] [PubMed]
- Shah, M.M.; Landen, C.N. Ovarian cancer stem cells: Are they real and why are they important? Gynecol. Oncol. 2014, 132, 483–489. [Google Scholar] [CrossRef] [PubMed]
- Baba, T.; Convery, P.A.; Matsumura, N.; Whitaker, R.S.; Kondoh, E.; Perry, T.; Huang, Z.; Bentley, R.C.; Mori, S.; Fujii, S.; et al. Epigenetic regulation of CD133 and tumorigenicity of CD133+ ovarian cancer cells. Oncogene 2009, 28, 209–218. [Google Scholar] [CrossRef] [PubMed]
- Kryczek, I.; Liu, S.L.; Roh, M.; Vatan, L.; Szeliga, W.; Wei, S.; Banerjee, M.; Mao, Y.J.; Kotarski, J.; Wicha, M.S.; et al. Expression of aldehyde dehydrogenase and CD133 defines ovarian cancer stem cells. Int. J. Cancer 2012, 130, 29–39. [Google Scholar] [CrossRef] [PubMed]
- Silva, I.A.; Bai, S.M.; McLean, K.; Yang, K.; Griffith, K.; Thomas, D.; Ginestier, C.; Johnston, C.; Kueck, A.; Reynolds, R.K.; et al. Aldehyde dehydrogenase in combination with CD133 defines angiogenic ovarian cancer stem cells that portend poor patient survival. Cancer Res. 2011, 71, 3991–4001. [Google Scholar] [CrossRef] [PubMed]
- Ma, S.; Chan, K.W.; Lee, T.K.W.; Tang, K.H.; Wo, J.Y.H.; Zheng, B.J.; Guan, X.Y. Aldehyde dehydrogenase discriminates the CD133 liver cancer stem cell populations. Mol. Cancer Res. 2008, 6, 1146–1153. [Google Scholar] [CrossRef] [PubMed]
- Choi, Y.J.; Ingram, P.N.; Yang, K.; Coffman, L.; Iyengar, M.; Bai, S.M.; Thomas, D.G.; Yoon, E.; Buckanovich, R.J. Identifying an ovarian cancer cell hierarchy regulated by bone morphogenetic protein 2. Proc. Natl. Acad. Sci. USA 2015, 112, E6882–E6888. [Google Scholar] [CrossRef] [PubMed]
- Vidal, S.J.; Rodriguez-Bravo, V.; Galsky, M.; Cordon-Cardo, C.; Domingo-Domenech, J. Targeting cancer stem cells to suppress acquired chemotherapy resistance. Oncogene 2014, 33, 4451–4463. [Google Scholar] [CrossRef] [PubMed]
- Meirelles, K.; Benedict, L.A.; Dombkowski, D.; Pepin, D.; Preffer, F.I.; Teixeira, J.; Tanwar, P.S.; Young, R.H.; MacLaughlin, D.T.; Donahoe, P.K.; et al. Human ovarian cancer stem/progenitor cells are stimulated by doxorubicin but inhibited by Mullerian inhibiting substance. Proc. Natl. Acad. Sci. USA 2012, 109, 2358–2363. [Google Scholar] [CrossRef] [PubMed]
- Soltanian, S.; Matin, M.M. Cancer stem cells and cancer therapy. Tumor Biol. 2011, 32, 425–440. [Google Scholar] [CrossRef] [PubMed]
- Burgos-Ojeda, D.; Rueda, B.R.; Buckanovich, R.J. Ovarian cancer stem cell markers: Prognostic and therapeutic implications. Cancer Lett. 2012, 322, 1–7. [Google Scholar] [CrossRef] [PubMed]
- Foster, R.; Buckanovich, R.J.; Rueda, B.R. Ovarian cancer stem cells: Working towards the root of sternness. Cancer Lett. 2013, 338, 147–157. [Google Scholar] [CrossRef] [PubMed]
- Flesken-Nikitin, A.; Hwang, C.I.; Cheng, C.Y.; Michurina, T.V.; Enikolopov, G.; Nikitin, A.Y. Ovarian surface epithelium at the junction area contains a cancer-prone stem cell niche. Nature 2013, 495, 241–245. [Google Scholar] [CrossRef] [PubMed]
- Abdullah, L.N.; Chow, E.K. Mechanisms of chemoresistance in cancer stem cells. Clin. Transl. Med. 2013, 2, 3. [Google Scholar] [CrossRef] [PubMed]
- Gurunathan, S.; Han, J.W.; Dayem, A.A.; Eppakayala, V.; Park, J.H.; Cho, S.G.; Lee, K.J.; Kim, J.H. Green synthesis of anisotropic silver nanoparticles and its potential cytotoxicity in human breast cancer cells (MCF-7). J. Ind. Eng. Chem. 2013, 19, 1600–1605. [Google Scholar] [CrossRef]
- Gurunathan, S.; Jeong, J.K.; Han, J.W.; Zhang, X.F.; Park, J.H.; Kim, J.H. Multidimensional effects of biologically synthesized silver nanoparticles in Helicobacter pylori, Helicobacter felis, and human lung (L132) and lung carcinoma A549 cells. Nanoscale Res. Lett. 2015, 10, 1–17. [Google Scholar] [CrossRef] [PubMed]
- Gurunathan, S.; Lee, K.J.; Kalishwaralal, K.; Sheikpranbabu, S.; Vaidyanathan, R.; Eom, S.H. Antiangiogenic properties of silver nanoparticles. Biomaterials 2009, 30, 6341–6350. [Google Scholar] [CrossRef] [PubMed]
- Swanner, J.; Mims, J.; Carroll, D.L.; Akman, S.A.; Furdui, C.M.; Torti, S.V.; Singh, R.N. Differential cytotoxic and radiosensitizing effects of silver nanoparticles on triple-negative breast cancer and non-triple-negative breast cells. Int. J. Nanomed. 2015, 10, 3937–3953. [Google Scholar]
- Gurunathan, S.; Kalishwaralal, K.; Vaidyanathan, R.; Deepak, V.; Pandian, S.R.K.; Muniyandi, J.; Hariharan, N.; Eom, S.H. Biosynthesis, purification and characterization of silver nanoparticles using Escherichia coli. Colloid Surf. B 2009, 74, 328–335. [Google Scholar] [CrossRef] [PubMed]
- Huang, E.H.; Hynes, M.J.; Zhang, T.; Ginestier, C.; Dontu, G.; Appelman, H.; Fields, J.Z.; Wicha, M.S.; Boman, B.M. Aldehyde dehydrogenase 1 is a marker for normal and malignant human colonic Stem Cells (SC) and tracks sc overpopulation during colon tumorigenesis. Cancer Res. 2009, 69, 3382–3389. [Google Scholar] [CrossRef] [PubMed]
- Gurunathan, S.; Han, J.W.; Park, J.H.; Kim, E.; Choi, Y.J.; Kwon, D.N.; Kim, J.H. Reduced graphene oxide-silver nanoparticle nanocomposite: A potential anticancer nanotherapy. Int. J. Nanomed. 2015, 10, 6257–6276. [Google Scholar] [CrossRef] [PubMed]
- Alon, N.; Miroshnikov, Y.; Perkas, N.; Gedanken, A.; Shefi, O. Substrates coated with silver nanoparticles promote neuronal growth. J. Mol. Neurosci. 2013, 51, S8. [Google Scholar]
- Qin, H.; Zhu, C.; An, Z.Q.; Jiang, Y.; Zhao, Y.C.; Wang, J.X.; Liu, X.; Hui, B.; Zhang, X.L.; Wang, Y. Silver nanoparticles promote osteogenic differentiation of human urine-derived stem cells at noncytotoxic concentrations. Int. J. Nanomed. 2014, 9, 2469–2478. [Google Scholar] [CrossRef] [PubMed]
- Verma, R.K.; Yu, W.; Singh, S.P.; Shankar, S.; Srivastava, R.K. Anthothecol-encapsulated PLGA nanoparticles inhibit pancreatic cancer stem cell growth by modulating sonic hedgehog pathway. Nanomed. Nanotechnol. 2015, 11, 2061–2070. [Google Scholar] [CrossRef] [PubMed]
- Gomez-Lechon, M.J.; O’Connor, E.; Castell, J.V.; Jover, R. Sensitive markers used to identify compounds that trigger apoptosis in cultured hepatocytes. Toxicol. Sci. 2002, 65, 299–308. [Google Scholar] [CrossRef] [PubMed]
- Gurunathan, S.; Park, J.H.; Han, J.W.; Kim, J.H. Comparative assessment of the apoptotic potential of silver nanoparticles synthesized by Bacillus tequilensis and Calocybe indica in MDA-MB-231 human breast cancer cells: Targeting p53 for anticancer therapy. Int. J. Nanomed. 2015, 10, 4203–4223. [Google Scholar] [CrossRef] [PubMed]
- Dayem, A.A.; Choi, H.-Y.; Kim, J.-H.; Cho, S.-G. Role of oxidative stress in stem, cancer, and cancer stem cells. Cancers 2010, 2, 859–884. [Google Scholar] [CrossRef] [PubMed]
- Ding, S.J.; Li, C.B.; Cheng, N.H.; Cui, X.J.; Xu, X.L.; Zhou, G.H. Redox Regulation in Cancer Stem Cells. Oxid. Med. Cell. Longev. 2015. [Google Scholar] [CrossRef] [PubMed]
- Zhang, B.B.; Wang, D.G.; Guo, F.F.; Xuan, C. Mitochondrial membrane potential and reactive oxygen species in cancer stem cells. Fam. Cancer 2015, 14, 19–23. [Google Scholar] [CrossRef] [PubMed]
- Diehn, M.; Cho, R.W.; Lobo, N.A.; Kalisky, T.; Dorie, M.J.; Kulp, A.N.; Qian, D.L.; Lam, J.S.; Ailles, L.E.; Wong, M.Z.; et al. Association of reactive oxygen species levels and radioresistance in cancer stem cells. Nature 2009, 458, 780–783. [Google Scholar] [CrossRef] [PubMed]
- Ye, X.Q.; Li, Q.; Wang, G.H.; Sun, F.F.; Huang, G.J.; Bian, X.W.; Yu, S.C.; Qian, G.S. Mitochondrial and energy metabolism-related properties as novel indicators of lung cancer stem cells. Int. J. Cancer 2011, 129, 820–831. [Google Scholar] [CrossRef] [PubMed]
- AshaRani, P.V.; Low Kah Mun, G.; Hande, M.P.; Valiyaveettil, S. Cytotoxicity and genotoxicity of silver nanoparticles in human cells. ACS Nano 2009, 3, 279–290. [Google Scholar] [CrossRef] [PubMed]
- Fulda, S.; Galluzzi, L.; Kroemer, G. Targeting mitochondria for cancer therapy. Nat. Rev. Drug Discov. 2010, 9, 447–464. [Google Scholar] [CrossRef] [PubMed]
- Hoffman, B.; Liebermann, D.A. Apoptotic signaling by C-MYC. Oncogene 2008, 27, 6462–6472. [Google Scholar] [CrossRef] [PubMed]
- Meletis, K.; Wirta, V.; Hede, S.M.; Nister, M.; Lundeberg, J.; Frisen, J. P53 suppresses the self-renewal of adult neural stem cells. Development 2006, 133, 363–369. [Google Scholar] [CrossRef] [PubMed]
- Wang, Y.H.; Scadden, D.T. Harnessing the apoptotic programs in cancer stem-like cells. EMBO Rep. 2015, 16, 1084–1098. [Google Scholar] [CrossRef] [PubMed]
- Hockenbery, D.; Nunez, G.; Milliman, C.; Schreiber, R.D.; Korsmeyer, S.J. Bcl-2 is an inner mitochondrial membrane protein that blocks programmed cell death. Nature 1990, 348, 334–336. [Google Scholar] [CrossRef] [PubMed]
- Qiu, B.; Wang, Y.; Tao, J. Expression and correlation of Bcl-2 with pathological grades in human glioma stem cells. Oncol. Rep. 2012, 28, 155–160. [Google Scholar] [PubMed]
- Tsujimoto, Y.; Shimizu, S. Bcl-2 family: Life-or-death switch. FEBS Lett. 2000, 466, 6–10. [Google Scholar] [CrossRef]
- Mak, D.H.; Wang, R.Y.; Schober, W.D.; Konopleva, M.; Cortes, J.; Kantarjian, H.; Andreeff, M.; Carter, B.Z. Activation of apoptosis signaling eliminates CD34(+) progenitor cells in blast crisis CML independent of response to tyrosine kinase inhibitors. Leukemia 2012, 26, 788–794. [Google Scholar] [CrossRef] [PubMed]
- Ma, X.; Zhou, J.; Zhang, C.X.; Li, X.Y.; Li, N.; Ju, R.J.; Shi, J.F.; Sun, M.G.; Zhao, W.Y.; Mu, L.M.; et al. Modulation of drug-resistant membrane and apoptosis proteins of breast cancer stem cells by targeting berberine liposomes. Biomaterials 2013, 34, 4452–4465. [Google Scholar] [CrossRef] [PubMed]
- Franken, N.A.P.; Rodermond, H.M.; Stap, J.; Haveman, J.; van Bree, C. Clonogenic assay of cells in vitro. Nat. Protoc. 2006, 1, 2315–2319. [Google Scholar] [CrossRef] [PubMed]

| Gene | Primers |
|---|---|
| Bcl2 | F: ATGTGTGTGGAGAGCGTCAA |
| R: GCCGGTTCAGGTACTCAGTC | |
| c-myc | F: AGCGACTCTGAGGAGGAACA |
| R: CTCTGACCTTTTGCCAGGAG | |
| p53 | F: TTTGGGTCTTTGAACCCTTG |
| R: CCACAACAAAACACCAGTGC | |
| Bax | F: ATGGAGCTGCAGAGGATGAT |
| R: CAGTTGAAGTTGCCGTCAGA | |
| Caspase-3 | F: CATACTCCACAGCACCTGGTTA |
| R: ACTCAAATTCTGTTGCCACCTT | |
| Bcl-xL | F: GTAAACTGGGGTCGCATTGT |
| R: CGATCCGACTCACCAATACC | |
| Bak | F: CTCAGAGTTCCAGACCATGTTG |
| R: CATGCTGGTAGACGTGTAGGG |
© 2016 by the authors; licensee MDPI, Basel, Switzerland. This article is an open access article distributed under the terms and conditions of the Creative Commons Attribution (CC-BY) license (http://creativecommons.org/licenses/by/4.0/).
Share and Cite
Choi, Y.-J.; Park, J.-H.; Han, J.W.; Kim, E.; Jae-Wook, O.; Lee, S.Y.; Kim, J.-H.; Gurunathan, S. Differential Cytotoxic Potential of Silver Nanoparticles in Human Ovarian Cancer Cells and Ovarian Cancer Stem Cells. Int. J. Mol. Sci. 2016, 17, 2077. https://doi.org/10.3390/ijms17122077
Choi Y-J, Park J-H, Han JW, Kim E, Jae-Wook O, Lee SY, Kim J-H, Gurunathan S. Differential Cytotoxic Potential of Silver Nanoparticles in Human Ovarian Cancer Cells and Ovarian Cancer Stem Cells. International Journal of Molecular Sciences. 2016; 17(12):2077. https://doi.org/10.3390/ijms17122077
Chicago/Turabian StyleChoi, Yun-Jung, Jung-Hyun Park, Jae Woong Han, Eunsu Kim, Oh Jae-Wook, Seung Yoon Lee, Jin-Hoi Kim, and Sangiliyandi Gurunathan. 2016. "Differential Cytotoxic Potential of Silver Nanoparticles in Human Ovarian Cancer Cells and Ovarian Cancer Stem Cells" International Journal of Molecular Sciences 17, no. 12: 2077. https://doi.org/10.3390/ijms17122077
APA StyleChoi, Y.-J., Park, J.-H., Han, J. W., Kim, E., Jae-Wook, O., Lee, S. Y., Kim, J.-H., & Gurunathan, S. (2016). Differential Cytotoxic Potential of Silver Nanoparticles in Human Ovarian Cancer Cells and Ovarian Cancer Stem Cells. International Journal of Molecular Sciences, 17(12), 2077. https://doi.org/10.3390/ijms17122077

